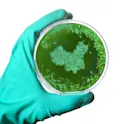

Open science and peer review
20 Oct 2015
Open Science and scholarly publishing roundup – October 17, 2015
Selected news, views and information on Open Science and scholarly publishing from the past week

Open science and peer review
20 Oct 2015
Selected news, views and information on Open Science and scholarly publishing from the past week

Open science and peer review
15 Oct 2015
Frontiers had the pleasure of attending The Open Access Tage 2015 on the 7th and 8th of September, this year at the University of Zurich.

Open science and peer review
13 Oct 2015
As a publisher, it is our duty to ensure that the business fundamentals behind Frontiers are sound and sustainable. We are responsible towards the community, to the more than 60,000 researchers who have formally joined our editorial boards, to the 140,000 authors who have published with us, and to our employees.

Open science and peer review
13 Oct 2015
Selected news, views and information on Open Science and scholarly publishing from the past week

Open science and peer review
07 Oct 2015
Not all people have equal access to science. In places where funds are particularly scarce, open access to science could bring fortune. Defining fortune The development of a country is officially measured with statistical indexes such as income per capita, gross domestic product, life expectancy and literacy. Science literacy is more subjective and is not normally considered a basic need; it is nonetheless, of great value for development of a country. From my tiny perspective, science literacy can enrich a population not only locally, by knowledge or application in specific fields, but also very profoundly in the form of wide-spread learning in proximity with the scientific reasoning. Exercising the scientific method builds critical thinking, favoring informed political choices, the adoption of healthier lives and sustainable interactions with the natural environment. Less developed countries tend to invest less in scientific training; often, this is due to their primary need to invest on basic education, health, and infrastructures for their population at large; sometimes it is due to a certain kind of political interest in keeping the population uninformed and conformed. In parallel, it remains a reality that publishing quality scientific articles and data has inherent costs. These are covered by the majority of […]

Open science and peer review
02 Oct 2015
Selected news, views and information on Open Science and scholarly publishing from the past week
Open science and peer review
23 Sep 2015
By Anthony King, science journalist. Chinese scientists are increasingly attracted to open access journals, particularly those with international reach and recognized kudos. With submissions from China on a steady rise, international publishers are eyeing up the market and beginning to tap into its vast potential. Of course, the open access model is gaining ground throughout the world, with nearly 10,000 journals now giving readers free access to research papers. China is no exception as its drive to internationalize and promote its scientific achievements draws researchers to submit to quality open access publications. Open access gets a boost At the end of 2013, open access journals represented about 16% [1,370 journals] of all academic journals in China. Although this proportion is not remarkable in itself, uptake has been extremely rapid since 2009. Chinese researchers and officials have traditionally been conservative about who they choose to work with and how they publish. Prestige and reputation count a lot and, until recently, open access publications did not carry the requisite authority or reach. But in just a few years this attitude has changed dramatically. Perhaps one of the biggest drivers for the upsurge in open access submissions is coming from the top–namely from […]

Open science and peer review
12 Sep 2015
Selected news, views and information on Open Science and scholarly publishing from the past week

Open science and peer review
11 Sep 2015
Click here for the 2017 analysis of the 2016 Journal Citation Reports by Clarivate Analytics (f.k.a. Thomson Reuters). July 16, 2016: An analysis of open-access journal performance in the 2015 Journal Citation Reports (JCR) revealed that Frontiers journals generated the #1 highest number of citations in the categories of Psychology, Neurosciences, Plant Sciences, Immunology, Neurology and Physiology and the #2 highest number of citations in the categories of Pharmacology & Pharmacy and Microbiology. Successful open-access journals grow quickly and are sometimes faced with the notion that publishing a large number of papers somehow decreases the overall quality. However, when looking at an analysis for the 19 Frontiers journals currently with impact factors, rankings soar as high as in the 94th percentile and on average were in the 85th percentile out of the 11,365 journals listed in the in the 2015 Journal Citations Reports published by Thomson Reuters in 2016 (See Figure 1). 2015 journal ranking by impact factor (11,365 journals) Figure 1: The 19 Frontiers journals with impact factors (in red) compared to the other 11,365 journals (subscription and open access) listed in the 2015 Journal Citation Reports. Frontiers ranks in the top 15% of Impact Factors for all journals, with our journals ranking between […]

Open science and peer review
07 Sep 2015
Selected news, views and information on Open Science and scholarly publishing from the past week

Open science and peer review
01 Sep 2015
In recent months, several academic publishers have been forced to retract a combined total of over 250 published articles across a number of disciplines due to irregularities and outright fraudulence in the peer-review process. As a result of this, the stringency of checks carried out by publishers during the submission and review process of manuscripts has come under the spotlight. Here, we give some background to this ongoing issue and discuss the various practices by which it can be contained. At the beginning of 2014, several journals under the aegis of a major publishing house were forced to retract 100+ papers when it was revealed that these papers had been “created” by SCIgen, a computer program that generates ‘random Computer Science research’ using context-free grammar. Later that year, a piece in Nature by retractionwatch.com activists Ivan Oransky, Cat Ferguson and Adam Marcus warned of the increasing danger of authors surreptitiously reviewing their own papers; an issue taken up by COPE (Committee on Publication Ethics) in a statement on 19 December 2014. Although ostensibly different issues, they both pointed towards problems residing at the core of academic publication – the soundness of peer-review. In March of this year, a Web of […]

Open science and peer review
28 Aug 2015
Selected news, views and information on Open Science and scholarly publishing from the past week
Open science and peer review
14 Aug 2015
By Chloe Schmidt and Katherine Lawson Submitting your first manuscript can be daunting to those who are unfamiliar with the process. To help clear up any uncertainty surrounding manuscript submission and peer review for first-timers, we’ve put together an illustrated guide of some of the basics. To see the Illustrated Beginner’s Guide to Peer Review in full size, either click on the image or download the PDF at this link:

Open science and peer review
11 Aug 2015
Selected news, views and information on Open Science and scholarly publishing from the past week

Open science and peer review
03 Aug 2015
Changes in scholarly publishing over the last 20 y include the emergence of preprint servers and the growth of OA. But other important changes have received less publicity. Richard Walker and Pascal Rocha da Silva discuss.
Get the latest research updates, subscribe to our newsletter